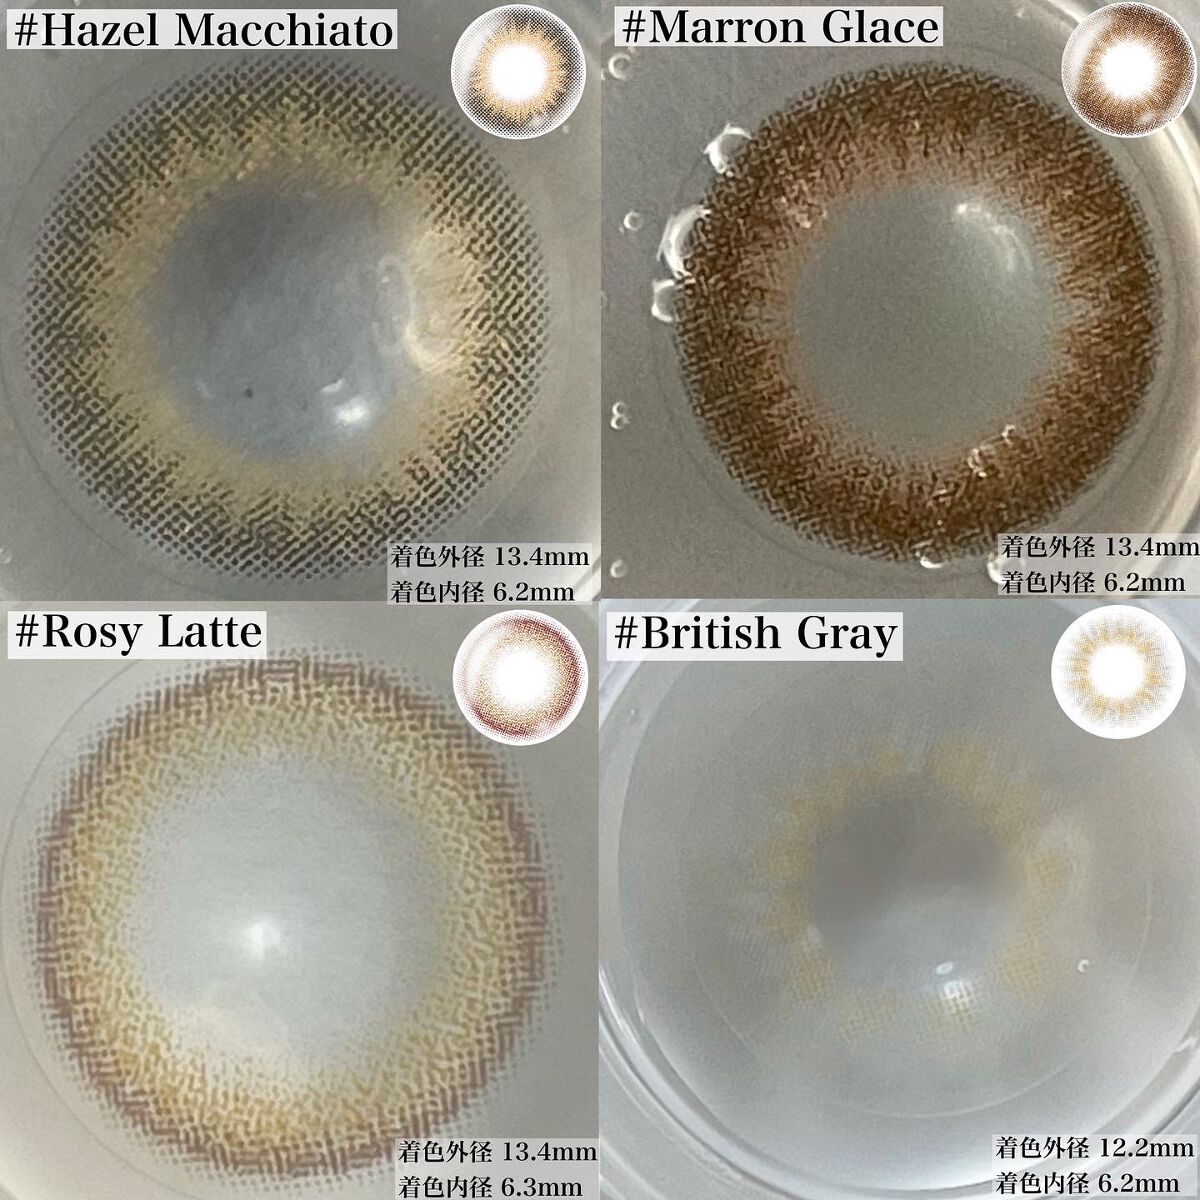

🍩enGiornoエクレアブラウン🍩使いきり!Qoo10のenGiorno公式ショップで¥1,500、メガ割だと980円で購入出来ました✨私が今回使い切ったのはエクレアブラウンというカラーでふんわりと盛れるタイプです✨濃いめブラウンなので黒目...
もっと見るカラーコンタクトレンズランキング
| 商品画像 | 商品情報 | 参考価格 | 評価 | ランキングIN | 特徴 | 商品リンク |
|---|---|---|---|---|---|---|
TOPARDS TOPARDS 1day | 1,760円 |
| カラコンランキング第2位 | 程よい盛れ感で年齢関係なく着けれるから推し度高い…! | 詳細を見る | |
MOLAK MOLAK 1day | 1,760円 |
| カラコンランキング第1位 | 今っぽいニュアンスカラコンを探している方に特にオススメしたいカラコンでした。 | 詳細を見る | |
エバーカラー エバーカラーワンデー ナチュラル | 2,598円 |
| カラコンランキング第3位 | 縁がぼかされているデザインと、優しいカラーの組み合わせで可愛らしい印象のカラコン | 詳細を見る | |
melotte melotte 1day | 1,793円 |
| カラコンランキング第4位 | つけてます感が無いのでさりげなく盛れます! 守りたくなるようなうるうるした瞳になって可愛い🥺 | 詳細を見る | |
FLANMY FLANMY 1day | 1,815円 |
| カラコンランキング第5位 | カラコンを使って簡単に儚いイメージをGET!ふんわり可愛い印象に近付けます。 | 詳細を見る | |
Chu's me Chu's me 1day | 1,705円 |
| カラコンランキング第6位 | 大きすぎず、小さすぎない「モテ比率」。男女受けOKな「カラーバリエーション」 | 詳細を見る | |
ReVIA ReVIA 1day | 1,870円 |
| カラコンランキング第7位 | ナチュラルなハーフ系カラコン☆ドットのぼかしでグラデされてて、瞳になじみやすくてGOOD | 詳細を見る | |
feliamo feliamo 1day | 1,760円 |
| カラコンランキング第8位 | すっごくナチュラル!!縁が綺麗にぼやけていて好きです☺️💕 | 詳細を見る | |
mimuco mimuco 1day | 1,705円 |
| カラコンランキング第9位 | どれもナチュラルなサイズ感で推しが決めれないくらい全色可愛いです🤲 | 詳細を見る | |
N’s COLLECTION N’s COLLECTION 1day | 1,760円 |
| カラコンランキング第11位 | メイクがいつもより映えて よりメイクが強調されるイメージでした! | 詳細を見る |
hanachanさんの人気クチコミ
このカラーは深い赤味のあるピンク。 ツヤ感もあってメイクした!って感じになる🥺 ティッシュオフすると色味も落ちるけど、ツヤ感はそのままで落ちても汚くないの。 濃いめのカラーでもムラにもなりづらくするする塗れる✨ 13番はすっぴんでも合わせやすいけど、12はメイクしてないと唇だけ目立つかな。 ナチュラルメイクやすっぴんの時に使いたい人は13。お出かけやお仕事で使いたい人は12がおすすめ。 プチプラでこのクオリティすごいよ… バズリップなだけある。 見つけたら即確保だよ!🤔✨
もっと見る
730
286
- 2022.10.02
まずこのSKYHIGH。 確かに液含みもよくてまつ毛に液が絡みやすくて塗りやすい。 一回塗っただけでもまつ毛が際立って仕上がり🙆♀️ 二度塗りしたら本当マツエク並みの長さになって大満足な仕上がりだった。 これ本当感動したよ✨ でも落ちない…本当最強ウォータープルーフ… 結論本当にマツエク並みにのびる。 でもコームやピンセットがあれば問題解決。 でも落ちない…本当最強ウォータープルーフ… クレンジングは選ばないとまだいる感が残る😭 あくまで私の使用感のレポだし、まつ毛本当伸びて盛れるから遊びに行く日とかメイクに合わせて普通に使ってるけどクレンジングだけ大変だよ🤔笑
もっと見る
668
113
- 2022.10.10
れっつとらい。みずみずしく輝き発光したようなツヤ肌に仕上げてくれるアイテム👀✨ 下地なんだけどリキッドハイライトとしても使えるんだって👌 チューブタイプで手に出すとみずみずしいテクスチャーで軽い塗り心地👀✨ 結構のびもよくてパールがキラキラしててキレイ🥺✨ 実際顔全体に塗るとキラキラ感もナチュラルで本当自然なツヤ感🥺! 白いカラーだったからちょい明るく見えるかなって思ってだけど塗るとクリア発色でほとんど色はつかなかった!
もっと見る
413
150
- 2023.12.16
密着ジェル膜でカバーして、透明感をフェイク✨ 私は一番気に入った03スノーライラックを買ってきたよ🙌 開封してみたら思ってた以上にパープルだった! 普段トーンアップしたいし、色ムラくすみをカバーしたいからパープルのコントロールカラーを使ってるんだけど、これは使わずにこれだけで大丈夫だった🙆♀️! 密着ジェル膜に変化する美容液ファンデーションでしっとり使用感✨ 正直濃いシミはカバーできなくて上からコンシーラー使ったり普段のファンデを薄く塗ったりもしてみたけど厚塗り感もでずいい感じだった👌! 思っていた以上に普通に使いやすくて、フェアピンクも気になる🥺! 専用ケースは別売りだよ!✨ 次にバズるのはこれかも👌!
もっと見る
396
133
- 2023.10.20
カラートナーは2カラーあって苔色グリーンと鉄色グレー! リップを塗る前に仕込むんだけど、上から塗るとくすみが足されてなっ馴染む!🤔 普通に好みなカラーにチェンジ🔥すごい! カラートナー、上から重ねるリップの塗る濃さで色味は調整できるから一本でも絶妙に色を変えられるのも🙆♀️!
もっと見る
386
87
- 2024.04.21
前回も投稿したんだけど(10/11の投稿です✍️)ぎゅんぎゅん伸びるのは知っていて、今回の新色も楽しみにしてた… その時にダークブラウンとかあったらいいなって言ってたんだけど…発売されちゃった👏アリガトウゴザイマス たそがれブラウンって名前にぴったりな少し赤みのあるブラウン✨ ブラック同様、繊維なしなのに一度塗りでしっかりのびる〜👀⤴︎ マスカラのブラシが不思議な形で(毎回食肉植物に見える。笑)アーチ状に並んだ5列のコームが目頭、目尻のまつ毛までしっかりキャッチしてくれるよ✨ 塗り重ねるごとに長さは出るんだけど重ねると多少ダマ?塊?みたいのが私は気になって(ならないって人もいるから塗り方が悪いのかな😂)ピンセットで整えてるよ✨! 02 たそがれブラウン 赤みブラウンで抜け感も出せて優しい目元になる✨ しかも絶妙なブラウンだから際立ち感もある。気分や、メイクによって使い分けするのもいいかも🥺✨
もっと見る
370
87
- 2023.02.08
商品詳細情報en Giorno アンジョルノ
- ブランド名
- en Giorno(アンジョルノ)
- 容量・参考価格
- 1箱2枚入: 1,500円
- 使用期限
- 1ヵ月 1ヶ月 1日 1ヶ月
- 着色直径
- 13.4mm 13.6mm
- DIA(レンズ直径)
- 14.2mm 14.4mm
- 度数
- ±0.00D(度なし)、-0.50D~-6.00D(-0.25Dステップ)、-6.50D~-9.00D(-0.50Dステップ)
- BC(ベースカーブ)
- 8.7mm
- 含水率
- 38% 38%
- 製造国
- 日本
- 高度管理医療機器
承認番号 - 30100BZX00027A03
- バリエーション
- メーカー名
- 粧美堂
- 発売日
- 2021/2/25(最新発売日: 2024/7/29)
- カテゴリ
- カラーコンタクトレンズ
![LIPS[リップス] - コスメのクチコミ検索アプリ](https://cdn.lipscosme.com/assets/lips_logo_full_2022-bc7b4bc9dd66035bc5696b0d16bc3d38a7be357186656c039e68cc4cf21ae675.png)

コメント